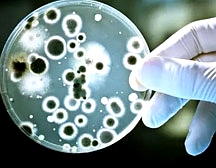
TitleContent

細胞實驗室建設介紹
細胞器培養是一項無菌操作技術,要求其工作環境及條件均無微生物污染,不受其他有害因素的影響。為防止微生物污染及有害因素的影響,要求工作環境干凈、空氣清新、干燥、無煙。細胞實驗室建設的設計原則是:無菌操作區設置在室內內部,走動較少,常規操作和封閉式培養在一間,而洗刷消毒在另一間。
細胞實驗室建設不同于其它物理化學實驗室,細胞實驗室要求有一個生物屏蔽區。簡而言之,這個細胞實驗室的空間,可以根據研究人員的主觀意識,確定該區域存在生命現象或僅存在一種特殊的生命體,否則,這一空間就無法稱之為細胞實驗室。
細胞實驗室建設需用鋁制框架搭配玻璃隔開,吊頂封閉而不會產生壓迫感,由相應的門與門洞相通,并設置紫外線消毒燈,確保日常環境保持無菌環境。實驗區的面積已經改變了對象的相應數量的超凈臺數和尺寸來調整,避免過大的空間浪費、過小就不方便,安裝新風和帶過濾通風裝置。
除上述內容外,還應設置一個普通的生物實驗空間,一般的細胞培養室面積40平方米就能滿足實驗需要,總體原理是布局合理,操作方便。與一般生物實驗室相似,作為細胞培養系統的支撐系統,應設置相應的固定臺面,以防止細胞培養皿的發生,并設置相關的儀器設備及簡單的細胞培養有菌操作實驗。